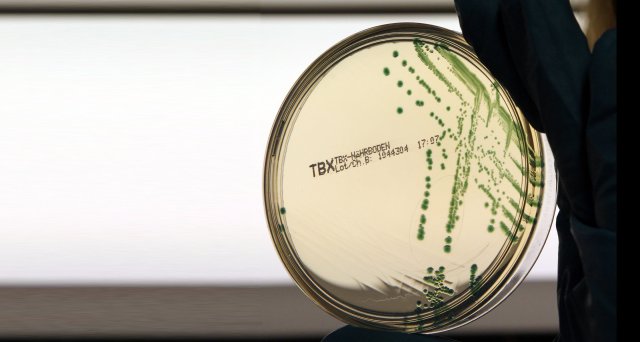
Dt_Aerzteblatt's tweet image. ECDC warnt vor Carbapenem-resistenten E. coli:  Stockholm – Im Europäischen Wirtschaftsraum (EU/EEA) breiten sich derzeit multiresistente Enterobakterien aus, die auch auf Carbapeneme, die zu den letzten effektiven… dlvr.it/TGS0Kz #ecdc #ecoli #antibiotikaresistenz

#ecoli search results
Doctor Mau Informa ®️ #drmauinforma #cancerdecolon #ecoli #colibactina #adn Fuente: Erik S. Carlson et al. ,The specificity and structure of DNA cross-linking by the gut bacterial genotoxin colibactin.Science390,eady3571(2025).
Out Now! Contaminated drinking water facilitates Escherichia coli strain-sharing within households in urban informal settlements bit.ly/44k5nBY #WaterQuality #Ecoli #AntibioticResistance

Equine activity in Matheran poses highest environmental and public health risk; NGT seeks response Read More Here- scctimes.com/4318mob0- #DrSujitKumarBajpayeeExpertMember #Ecoli #EcoliSensitiveZone #environmentaldegradation #equineactivity #faecalcontamination #formalparty

En @CMIComms REVISIÓN✍🏻 uso de #FOSFOMICINA trometamol en #Ecoli y #Enterococo, NO en #Klebsiella por alto% gen #fosA q la haría R, incluye: 🔹Cistitis🚽 🔹Embarazadas🤰🏻 🔹Enf renal crónica 🔹ITU complicada😈 🔹Prostatitis 🔹Profilaxis ITU recurrente🔁 🔗🆓sciencedirect.com/science/articl…



Fascinating insights from MSK gastrointestinal medical oncologist @KarunaMDPhD on the role of #Ecoli in age-dependent cell cycle entry for early onset #colorectal cancer initiation. #AACR25 @AACR


Scientists link animals to E. coli movement in central California #ecoli #FDA #foodsafety agri-pulse.com/articles/24332…
🦠Just published! This new review is the first of its kind to explore the prevalence and distribution of Shiga toxin-producing E. coli (STEC) in developing countries. It compares local trends to global patterns. 🔎Read more: mdpi.com/2076-2607/13/7… #Shiga #toxin #Ecoli

Raw Farm LLC says the limited recall is being issued “under protest” and “as a path forward,” while continuing to contest the epidemiological evidence provided by FDA. #foodsafety #ecoli #rawdairy 👉 MORE: brnw.ch/21x1iPU

New research in #GENETICS from @AndyArsham and colleagues shows how a #Ecoli lac operator can form ectopic heterochromatin in the #Drosophila genome, resulting in a distinct histone modification pattern and an unusual temperature sensitivity. buff.ly/AlzAqQD

Naukowcy przepisali genom E. coli: Syn57 działa na uproszczonym kodzie — usunęli 7 kodonów i dokonali ~101 tys. zmian w genomie. Możliwa odporność na wirusy i nowa platforma dla leków i materiałów. 🔬🧬 #biologiasyntetyczna #Ecoli android.com.pl/nauka/964161-n…
A structural analysis of #Ecoli RecBCD enzyme reveals a new RecB tether–RecC groove crosspoint interactions required for Chi recombination hotspot sequence regulation. buff.ly/D2pxGZS

#Bacteriophage cocktail in drinking water suppresses systemic avian pathogenic Escherichia coli infection and pathology in laying hens sciencedirect.com/science/articl… #OpenAccess #Ecoli #phages #microbiology

#ThermoFisher has expanded its chemically defined media for #Ecoli #biomanufacturing. The new media are designed to improve #plasmidDNA and #recombinantprotein production while simplifying #microbial #bioprocessing workflows. pharmamanufacturing.com/industry-news/… #Escherichiacoli #mRNAvaccines
#CostaRica: #Ecoli outbreak sickens more than 100 at #Alajuela prison open.substack.com/pub/outbreakne…

The Public Health Agency of Canada is reporting a fifth hospitalization in an E. coli outbreak linked to recalled Pillsbury brand Pizza Pops. #recall #ecoli #health #pizzapops cjme.com/2025/12/24/fiv…
The latest study in #GENETICS debunks a decades-old claim about nuclease in #Ecoli. Read more here about the experiments that helped conclude that the RecBCD nuclease repairs broken DNA but fails to destroy phage DNA: buff.ly/OnZwpMD

Επιστήμονες δημιούργησαν ενώσεις με αντικαρκινικές και αντιφλεγμονώδεις ιδιότητες από βακτήρια E.coli - #OkNewsGr #ecoli #βακτήρια oknews.gr/?p=442248
E. coli Converts Plastic Waste Into Parkinson’s Drug L-DOPA #Ecoli can transform the PET-derived chemical building blocks from converted post-consumer plastic bottles into the drug compound L-DOPA @Dr_StephenW @EdinburghUni #Parkinsons #bioengineering hubs.li/Q0476XSR0
Using a transparent soil mimic and the model bacterium #Ecoli, researchers characterized how soil texture affects bacterial motility across pore scales, finding bacteria shift from run-and-tumble behavior in large pores to frequent trapping in small ones. go.aps.org/4lJCCFG

Nearly 200 cases. Salmonella in Canada. E. coli linked to raw cheddar. Different outbreaks. Same issue 👇 Gaps in food safety systems. If this happened in your operation, would your system catch it early? #FoodSafety #Ecoli #Salmonella #HACCP

Boil Water Advisory — Kannapolis: E. coli detected. Boil all water for 1 minute. Free water at 933 Floyd St after 2 PM. Share with anyone in the area. Details: wix.to/YrQgfe2 #BoilWater #Kannapolis #Ecoli #HealthAlert
Terkuak Bahaya Ikan Sapu-Sapu, E Coli 100 Kali di Atas Batas, Dokter Ungkap Risiko Mengerikan #BahayaIkanSapuSapu #Ecoli aceh.tribunnews.com/news/1022185/t…
Purple-Haired Congresswoman LOSES HER S#*T!!! #RosaDeLauro #MAHA #Ecoli youtu.be/LLjkd9nhrwI?si… via @YouTube
youtube.com
YouTube
Don't Walk, Run! Productions
A number of municipalities are under scrutiny after #ecoli contamination was detected in drinking water at schools within their jurisdictions, raising concerns about compliance with basic water quality standards. For more: insidemetros.co.za/2026/04/22/mun… #waterquality #insidemetros

Congratulations to Ms. Bhosale Ankita Anil on her successful PhD defense at BRIC-CDFD 👏 Her work on transcription terminator Rho in E. coli adds valuable insights into gene regulation. @IndiaDST | @BricDbt | @DBTIndia #PhDDefense #Ecoli #GeneRegulation #Microbiology #CDFD

After an @FBIIndianapolis investigation, a Chinese researcher and former Indiana University professor pled guilty to smuggling E. coli into the U.S. and lying about his CCP membership

Among 359 outbreak-linked Shiga toxin–producing #Ecoli (#STEC) infections beginning in daycare centers in Calgary, only 7% of infected children developed HUS. Early, coordinated care with daily lab monitoring identified all future HUS cases. ja.ma/3QaHTub

💥Excited for the publication: "Manipulating Intracellular Oxidative Conditions to Enhance Porphyrin Production in <i>Escherichia coli</i>" 🔗brnw.ch/21x1FvC 📌 #SyntheticBiology #Biotechnology #Ecoli #Bioproduction #Bioengineering #SystemsBiology #Bioprocessing

RAW FARM Branded Raw Milk and Cheddar Cheese Contain E. coli Bacteria. E. coli can trigger serious and life-threatening gastrointestinal and systemic infections. #RecallAlert #FoodSafety #Ecoli #HealthWarning #ProductRecall
Raw milk containing a deadly bacteria is a fact, and a recall is needed to save lives. #MAHA #Ecoli #Recall washingtonpost.com/opinions/2026/…
washingtonpost.com
Opinion | This is a tale of two outbreaks. The difference is RFK Jr.
These raw dairy E. coli outbreaks are exposing something troubling.
Given the crap Trump eats, it's amazing he's still alive #McDonalds #Ecoli 🤮
Scientists discover how #bacteria rotate tiny pucks ... | #Ecoli | #MicroSky | #metallurgy | #infection | #contamination | By @istaresearch.bsky.social via @sciencex.bsky.social buff.ly/xW103Oo
Zo'n hekel aan die gasten met die zwarte nitril handschoenen zowel rauw als bereid vlees aanraken #kruisbesmetting #salmonella #ecoli
#Microbial #hockey ... | #Ecoli | #flagella | #microbiology | #biofilms | By @istaresearch.bsky.social via @eurekalert.bsky.social buff.ly/CnR7WWq
🧀 The president of @Raw_Farm said that it “blows my mind” that the #FDA has linked the company’s #rawcheese to an #Ecoli outbreak. vist.ly/4xpgg
Hastalıktan ari işletmelerde gebe büyükbaş hayvanlara yönelik aşılama yapıldı. Rota, corona ve #EColi enfeksiyonlarına karşı koruma sağlanarak buzağı sağlığı destekleniyor. Koruyucu hekimlik çalışmalarıyla #HayvanSağlığı güçlendiriliyor.



En @CMIComms REVISIÓN✍🏻 uso de #FOSFOMICINA trometamol en #Ecoli y #Enterococo, NO en #Klebsiella por alto% gen #fosA q la haría R, incluye: 🔹Cistitis🚽 🔹Embarazadas🤰🏻 🔹Enf renal crónica 🔹ITU complicada😈 🔹Prostatitis 🔹Profilaxis ITU recurrente🔁 🔗🆓sciencedirect.com/science/articl…



Nine #Ecoli O157:H7 cases across three states have been linked to Raw Farm-brand raw cheddar cheese. Raw Farm initiated a voluntary recall April 2 while FDA conducts inspections and testing with state partners. 🔗 Update: ow.ly/pmEG50YF3OC #foodsafety #publichealth


🦠 A California dairy producer recalled its #rawcheese but says there’s no proof its product made from #rawmilk has caused an #Ecoli outbreak, which the FDA is investigating. Read here ⬇️ vist.ly/4xj5b
🦠Just published! This new review is the first of its kind to explore the prevalence and distribution of Shiga toxin-producing E. coli (STEC) in developing countries. It compares local trends to global patterns. 🔎Read more: mdpi.com/2076-2607/13/7… #Shiga #toxin #Ecoli

Out Now! Contaminated drinking water facilitates Escherichia coli strain-sharing within households in urban informal settlements bit.ly/44k5nBY #WaterQuality #Ecoli #AntibioticResistance

New work this week expands scientific knowledge of the small proteins that coordinate stress responses in bacteria, such as #Ecoli, and suggests that cellular stress networks are more interconnected than was previously thought. @ScarletSam @Waksman_Inst scim.ag/3HEwnTT

The latest study in #GENETICS debunks a decades-old claim about nuclease in #Ecoli. Read more here about the experiments that helped conclude that the RecBCD nuclease repairs broken DNA but fails to destroy phage DNA: buff.ly/OnZwpMD

🦠Un estudio reveló cómo las polimixinas, antibióticos de último recurso, logran destruir la "armadura" de bacterias resistentes como la #EColi 🔬 Un avance clave en la lucha contra infecciones graves consalud.es/saludigital/in…

#CostaRica: #Ecoli outbreak sickens more than 100 at #Alajuela prison open.substack.com/pub/outbreakne…

Additional Pillsbury brand Pizza Pops have been recalled as part of an E.coli outbreak. There are now 29 cases in 7 provinces. Do not consume, use, serve, or sell the recalled products. ow.ly/Wg7z50Y45qP #EColi

What are the roles of small proteins in #Ecoli? Using ribosome profiling, a team studies small proteins induced by magnesium starvation and show that one named YoaI activates a two-component system linked to osmotic stress response. @ScarletSam scim.ag/3HEwnTT

Even bacteria have a Plan B. When the usual machinery for copying #EColi’s DNA stalls, a protein called PriC jumps in to restart the process, keeping the cell alive under stress. A clever backup system hiding in plain sight. elifesciences.org/articles/10737…

En @CMIComms REVISIÓN✍🏻 uso de #FOSFOMICINA trometamol en #Ecoli y #Enterococo, NO en #Klebsiella por alto% gen #fosA q la haría R, incluye: 🔹Cistitis🚽 🔹Embarazadas🤰🏻 🔹Enf renal crónica 🔹ITU complicada😈 🔹Prostatitis 🔹Profilaxis ITU recurrente🔁 🔗🆓sciencedirect.com/science/articl…



Bile acids create an oxygen-rich environment in the mouse colon that encourages the growth of potentially pathogenic #Enterobacteriaceae, such as #Ecoli, according to a new analysis of cells and patients with Crohn’s disease. @FinlayLab @ubcmsl scim.ag/4goVDd0

Don't take chances. Drink bourbon. . #bourbon #whiskey #ecoli #foodsafety #vegetables #fruit #bourbonbrotherhood #thanksgiving #whiskeyhumor #bourbonfun

#Ecoli outbreak rises to 90, Most people are reporting eating the #QuarterPounder hamburger at #McDonalds before becoming sick open.substack.com/pub/outbreakne…

ECDC warnt vor Carbapenem-resistenten E. coli: Stockholm – Im Europäischen Wirtschaftsraum (EU/EEA) breiten sich derzeit multiresistente Enterobakterien aus, die auch auf Carbapeneme, die zu den letzten effektiven… dlvr.it/TGS0Kz #ecdc #ecoli #antibiotikaresistenz
Raw Farm LLC says the limited recall is being issued “under protest” and “as a path forward,” while continuing to contest the epidemiological evidence provided by FDA. #foodsafety #ecoli #rawdairy 👉 MORE: brnw.ch/21x1iPU

Congratulations to Ms. Bhosale Ankita Anil on her successful PhD defense at BRIC-CDFD 👏 Her work on transcription terminator Rho in E. coli adds valuable insights into gene regulation. @IndiaDST | @BricDbt | @DBTIndia #PhDDefense #Ecoli #GeneRegulation #Microbiology #CDFD

Carrots Recalled From US-Based Stores Following Deadly E. Coli Outbreak food.ndtv.com/news/carrots-i… #carrots #Ecoli #outbreak

Fascinating insights from MSK gastrointestinal medical oncologist @KarunaMDPhD on the role of #Ecoli in age-dependent cell cycle entry for early onset #colorectal cancer initiation. #AACR25 @AACR


Cuánto RIESGO tiene tu 🫵🏻paciente COLONIZADO por BLEE de que la infección ACTUAL 🫁🚽🧠🩸sea por #Kpneumoniae o #Ecoli BLEE? Calcúlalo con la #CALCULADORA🧮 de 👉🏻esblrisk.com📸👇🏻‼️ Basada en publicación 📖@ASHE_Journal 🔗🆓cambridge.org/core/journals/…



🦠 Foodborne illness outbreaks announced in December have sickened 131 people, according to CDC and FDA reports. Salmonella, Listeria, E. coli—and infant botulism—are under investigation. idse.net/a/5DUBAA/t #ecoli #botulism

Something went wrong.
Something went wrong.
United States Trends
- 1. Good Monday N/A
- 2. #metgala2026 N/A
- 3. #euphoria N/A
- 4. #MondayMotivation N/A
- 5. Manus N/A
- 6. 60 Minutes N/A
- 7. Pied Piper N/A
- 8. Cassie N/A
- 9. Carville N/A
- 10. Oilers N/A
- 11. Nate N/A
- 12. Edmonton N/A
- 13. #BokBear N/A
- 14. Kimmel N/A
- 15. #FlyTogether N/A
- 16. Maddy N/A
- 17. Norah O'Donnell N/A
- 18. Frame N/A
- 19. Ducks N/A
- 20. Hoss N/A




























































































